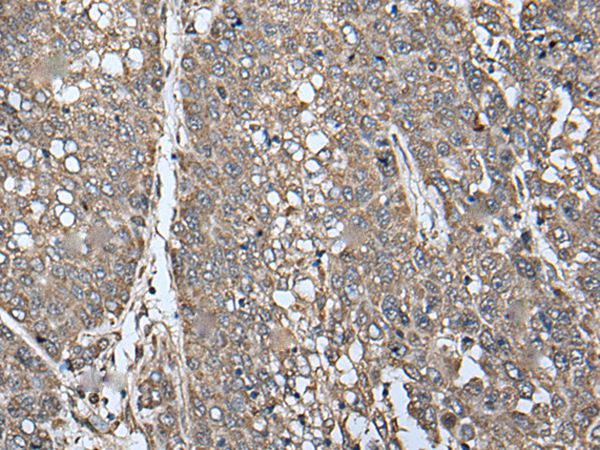
Anti-ATAD1 Antibody

Immunohistochemical staining of human kidney shows strong cytoplasmic positivity in a subset of tubules.
Anti-ATAD1 Antibody
HPA037569
ApplicationsImmunoCytoChemistry, ImmunoHistoChemistry
Product group Antibodies
ReactivityHuman
TargetATAD1
Overview
- SupplierAtlas Antibodies
- Product NameAnti-ATAD1 Antibody
- Delivery Days Customer4
- ApplicationsImmunoCytoChemistry, ImmunoHistoChemistry
- CertificationResearch Use Only
- ClonalityPolyclonal
- ConjugateUnconjugated
- Gene ID84896
- Target nameATAD1
- Target descriptionATPase family AAA domain containing 1
- Target synonymsAFDC1, FNP001, HKPX4, Msp1, THORASE, hATAD1, outer mitochondrial transmembrane helix translocase, ATPase family AAA domain-containing protein 1
- HostRabbit
- IsotypeIgG
- Protein IDQ8NBU5
- Protein NameOuter mitochondrial transmembrane helix translocase
- Scientific DescriptionRecombinant Protein Epitope Signature Tag (PrEST) antigen sequence
- ReactivityHuman
- Storage Instruction-20°C,2°C to 8°C
- UNSPSC41116161